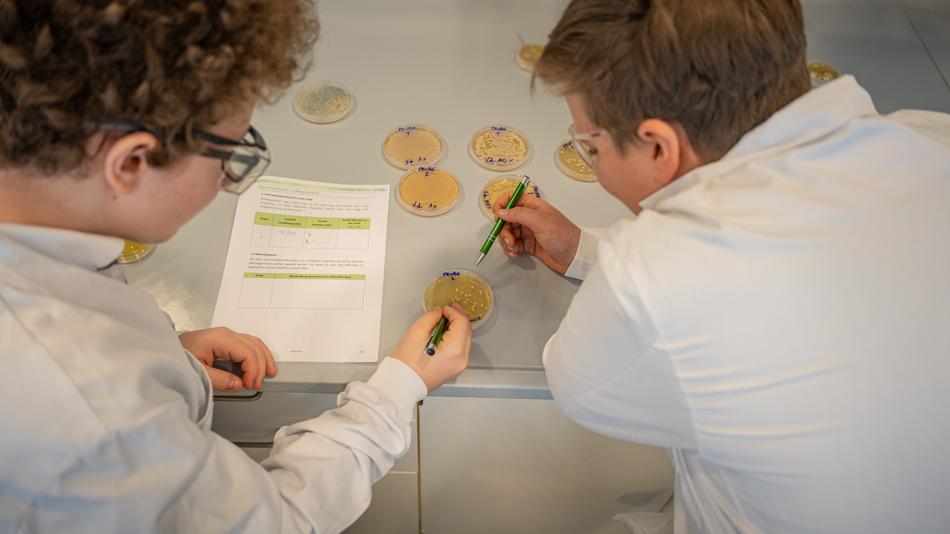
Arbeiten im Chemielabor
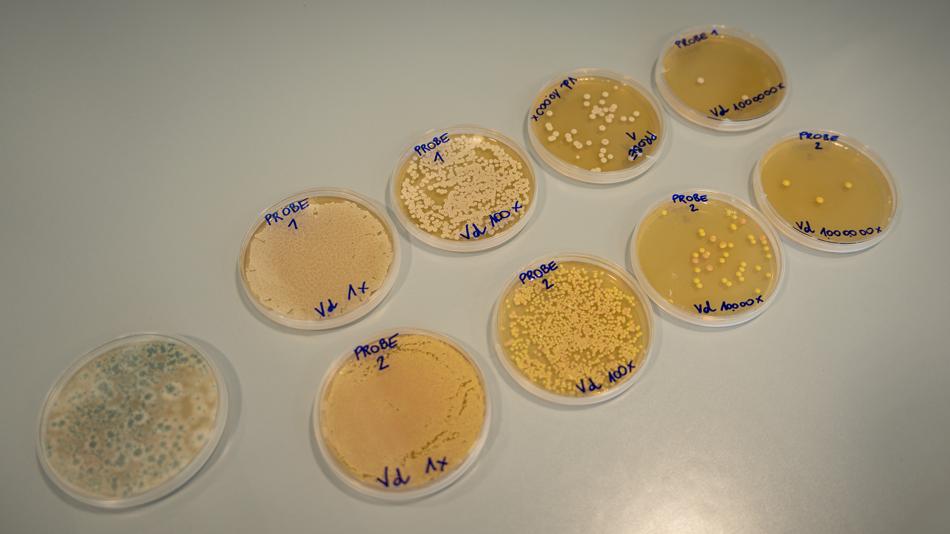
Arbeiten im Chemielabor

Experiment / Vorführung
Axils: Wie fühlt sich Arbeiten im Chemielabor an?
Durchschnittliche Verweildauer: 10 Minuten
Maximale Kapazität der Station: 5 Personen
Bei dieser Station der Langen Nacht der Forschung tauchen Besucher:innen in die faszinierende Welt der chemischen Lehrberufe im Life-Sciences-Bereich ein. Die Ausbildungsrichtungen Chemieverfahrenstechnik und Labortechnik werden anschaulich vorgestellt und mit praxisnahen Mitmachstationen erlebbar gemacht.
An einem Mikroskop können Bakterien und Pilze aus nächster Nähe und im Detail betrachtet werden – ein spannender Einblick in die tägliche Arbeit im Labor. Zudem werden pH-Werte von alltäglichen Haushaltsmitteln bestimmt, um zu zeigen, wie Chemie unseren Alltag beeinflusst. Beim Pipettieren lernen die Besucher:innen eine der wichtigsten Grundfertigkeiten im Labor kennen und können selbst präzises Arbeiten ausprobieren.
Die Station der AXILS GmbH vermittelt, wie vielseitig, modern und zukunftsorientiert chemische Lehrberufe sind, und zeigt, welche Rolle sie in Forschung, Industrie und Life Sciences spielen.
Besucherinformation
Anfahrtsbeschreibung: Die Veranstaltung findet im Health Hub Tirol (Exlgasse 24, 6020 Innsbruck) statt. Wir empfehlen die Anreise mit öffentlichen Verkehrsmittel bzw. die Nutzung des kostenlosen Shuttlebus. Mit den IVB erreichen Sie den Veranstaltungsort über die Bushaltestelle Innsbruck Exlgasse (Stadtbus F), die etwa 2 Gehminuten entfernt liegt. Die aktuellen Fahrpläne finden Sie unter www.ivb.at.
Dieser Ausstellungsstandort ist barrierefrei zugänglich.
Öffnungszeiten
Kontakt
Information
Vorstellung der Lehrberufe Chemieverfahrenstechnik & Labortechnik
Einblick in Chemieverfahrenstechnik & Labortechnik
Mikroskopieren: Beobachtung von Bakterien & Pilzen – ein Blick in die faszinierende Welt des Unsichtbaren
pH-Wert-Experimente: Untersuchung von Haushaltsmitteln und Erklärung, was Säuren und Basen sind
Bedienen von Transfer-Pipetten: Selbst ausprobieren, wie genau und sorgfältig im Labor gearbeitet wird
7 weitere Stationen an diesem Standort
-
 MitmachstationCyprumed: Was sind orale pharmazeutische Arzneiformen und wie unterscheiden sich Tabletten, Kapseln und orale Lösungen in ihrer Anwendung und Funktion?Thema: Gesundheit NaturwissenschaftenDas Verhalten von unterschiedlichen oralen Arzneiformen kann beobachtet und getestet werden.Health Hub Tirol17:00 - 23:00
MitmachstationCyprumed: Was sind orale pharmazeutische Arzneiformen und wie unterscheiden sich Tabletten, Kapseln und orale Lösungen in ihrer Anwendung und Funktion?Thema: Gesundheit NaturwissenschaftenDas Verhalten von unterschiedlichen oralen Arzneiformen kann beobachtet und getestet werden.Health Hub Tirol17:00 - 23:00 -
 MitmachstationFraunhofer: Wie unterstützt Künstliche Intelligenz das Backen von Brot?Thema: Digitalisierung TechnikErleben Sie, wie Künstliche Intelligenz, Sensorik und Sprachassistenz traditionelle Backprozesse verbessern. Von der Wissenssicherung über smarte Öfen bis zur Vermeidung von Backfehlern – entdecken Sie, wie Technik Qualität steigert, Prozesse transparent macht und Backwissen für die Zukunft erhält.Health Hub Tirol17:00 - 23:00
MitmachstationFraunhofer: Wie unterstützt Künstliche Intelligenz das Backen von Brot?Thema: Digitalisierung TechnikErleben Sie, wie Künstliche Intelligenz, Sensorik und Sprachassistenz traditionelle Backprozesse verbessern. Von der Wissenssicherung über smarte Öfen bis zur Vermeidung von Backfehlern – entdecken Sie, wie Technik Qualität steigert, Prozesse transparent macht und Backwissen für die Zukunft erhält.Health Hub Tirol17:00 - 23:00 -
Experiment / VorführungHealink: Kann man Blutzucker messen ohne einen Tropfen Blut?Thema: Digitalisierung GesundheitLifeSense zeigt, wie Blutzucker künftig ganz ohne Blutstropfen gemessen werden könnte. Besuchende erfahren, wie Licht, Puls und Temperatur genutzt werden, um Werte nicht-invasiv zu bestimmen. An unserer Ausstellung erklären Forschende die Technologie hinter Healink und geben spannende Einblicke in die Entwicklung eines innovativen Medizinprodukts.Health Hub Tirol17:00 - 23:00
-
 ShowprogrammOroboros&KinCon: Wie wirken Medikamente auf molekulare Maschinen (Proteine) und die Energiekraftwerke unserer Zellen (Mitochondrien)?Thema: Gesundheit NaturwissenschaftenMitochondrien (Zellkraftwerke) und Proteine (molekulare Maschinen) sind zentral für den Körper. Oroboros Instruments und KinCon biolabs kombinieren ihre Technologien zur Analyse von Mitochondrien und krankheitsrelevanten Proteinen, um Arzneimittelentwicklung präziser, schneller und sicherer zu machen und Nebenwirkungen früh zu erkennen und zu minimieren. Das fördert Diagnose und Verständnis vieler Krankheiten.Health Hub Tirol17:00 - 23:00
ShowprogrammOroboros&KinCon: Wie wirken Medikamente auf molekulare Maschinen (Proteine) und die Energiekraftwerke unserer Zellen (Mitochondrien)?Thema: Gesundheit NaturwissenschaftenMitochondrien (Zellkraftwerke) und Proteine (molekulare Maschinen) sind zentral für den Körper. Oroboros Instruments und KinCon biolabs kombinieren ihre Technologien zur Analyse von Mitochondrien und krankheitsrelevanten Proteinen, um Arzneimittelentwicklung präziser, schneller und sicherer zu machen und Nebenwirkungen früh zu erkennen und zu minimieren. Das fördert Diagnose und Verständnis vieler Krankheiten.Health Hub Tirol17:00 - 23:00 -
Experiment / VorführungSyncVR Medical: Wie kann Virtual Reality Anatomie und chirurgische Fertigkeiten erlebbar machen?Thema: Digitalisierung GesundheitErleben Sie mit zwei VR-Stationen, wie Anatomie und Chirurgie in Virtual Reality trainiert werden können. Besuchende erkunden im virtuellen Präpariersaal detailgetreu den menschlichen Körper und üben chirurgische Handgriffe in realitätsnahen Simulationen, ohne Risiko für Patientinnen und Patienten.SyncVR Medical DE GmbH17:00 - 23:00
-
 MitmachstationVASCAGE: Wie unterstützt eine EEG-basierte Brain-Computer-Schnittstelle die Neurorehabilitation nach Schlaganfall?Thema: Digitalisierung GesundheitVASCage erforscht gemeinsam mit g.tec den evidenzbasierten Einsatz digitaler Neurotechnologien in der Schlaganfallrehabilitation. Das recoveriX-System ist eine EEG-basierte Gehirn-Computer-Schnittstelle, die motorische Vorstellung in Echtzeit erkennt und über funktionelle Elektrostimulation rückkoppelt. An der Mitmachstation demonstrieren wir das System und seine forschungsbasierte Weiterentwicklung.Health Hub Tirol17:00 - 23:00
MitmachstationVASCAGE: Wie unterstützt eine EEG-basierte Brain-Computer-Schnittstelle die Neurorehabilitation nach Schlaganfall?Thema: Digitalisierung GesundheitVASCage erforscht gemeinsam mit g.tec den evidenzbasierten Einsatz digitaler Neurotechnologien in der Schlaganfallrehabilitation. Das recoveriX-System ist eine EEG-basierte Gehirn-Computer-Schnittstelle, die motorische Vorstellung in Echtzeit erkennt und über funktionelle Elektrostimulation rückkoppelt. An der Mitmachstation demonstrieren wir das System und seine forschungsbasierte Weiterentwicklung.Health Hub Tirol17:00 - 23:00 -
 RahmenprogrammInformationsstand der Standortagentur Tirol GmbHThema: WirtschaftDie Standortagentur Tirol, ein Unternehmen der Lebensraum Tirol Holding ist im Rahmen der Langen Nacht der Forschung für die Organisation und Koordination der forschenden Tiroler Unternehmen verantwortlich. Am Stand im Health Hub Tirol und erhalten Sie Informationen zum Tiroler Clusternetzwerk und dem vielfältigen Aufgabenbereich der Standortagentur Tirol.Health Hub Tirol17:00 - 23:00
RahmenprogrammInformationsstand der Standortagentur Tirol GmbHThema: WirtschaftDie Standortagentur Tirol, ein Unternehmen der Lebensraum Tirol Holding ist im Rahmen der Langen Nacht der Forschung für die Organisation und Koordination der forschenden Tiroler Unternehmen verantwortlich. Am Stand im Health Hub Tirol und erhalten Sie Informationen zum Tiroler Clusternetzwerk und dem vielfältigen Aufgabenbereich der Standortagentur Tirol.Health Hub Tirol17:00 - 23:00